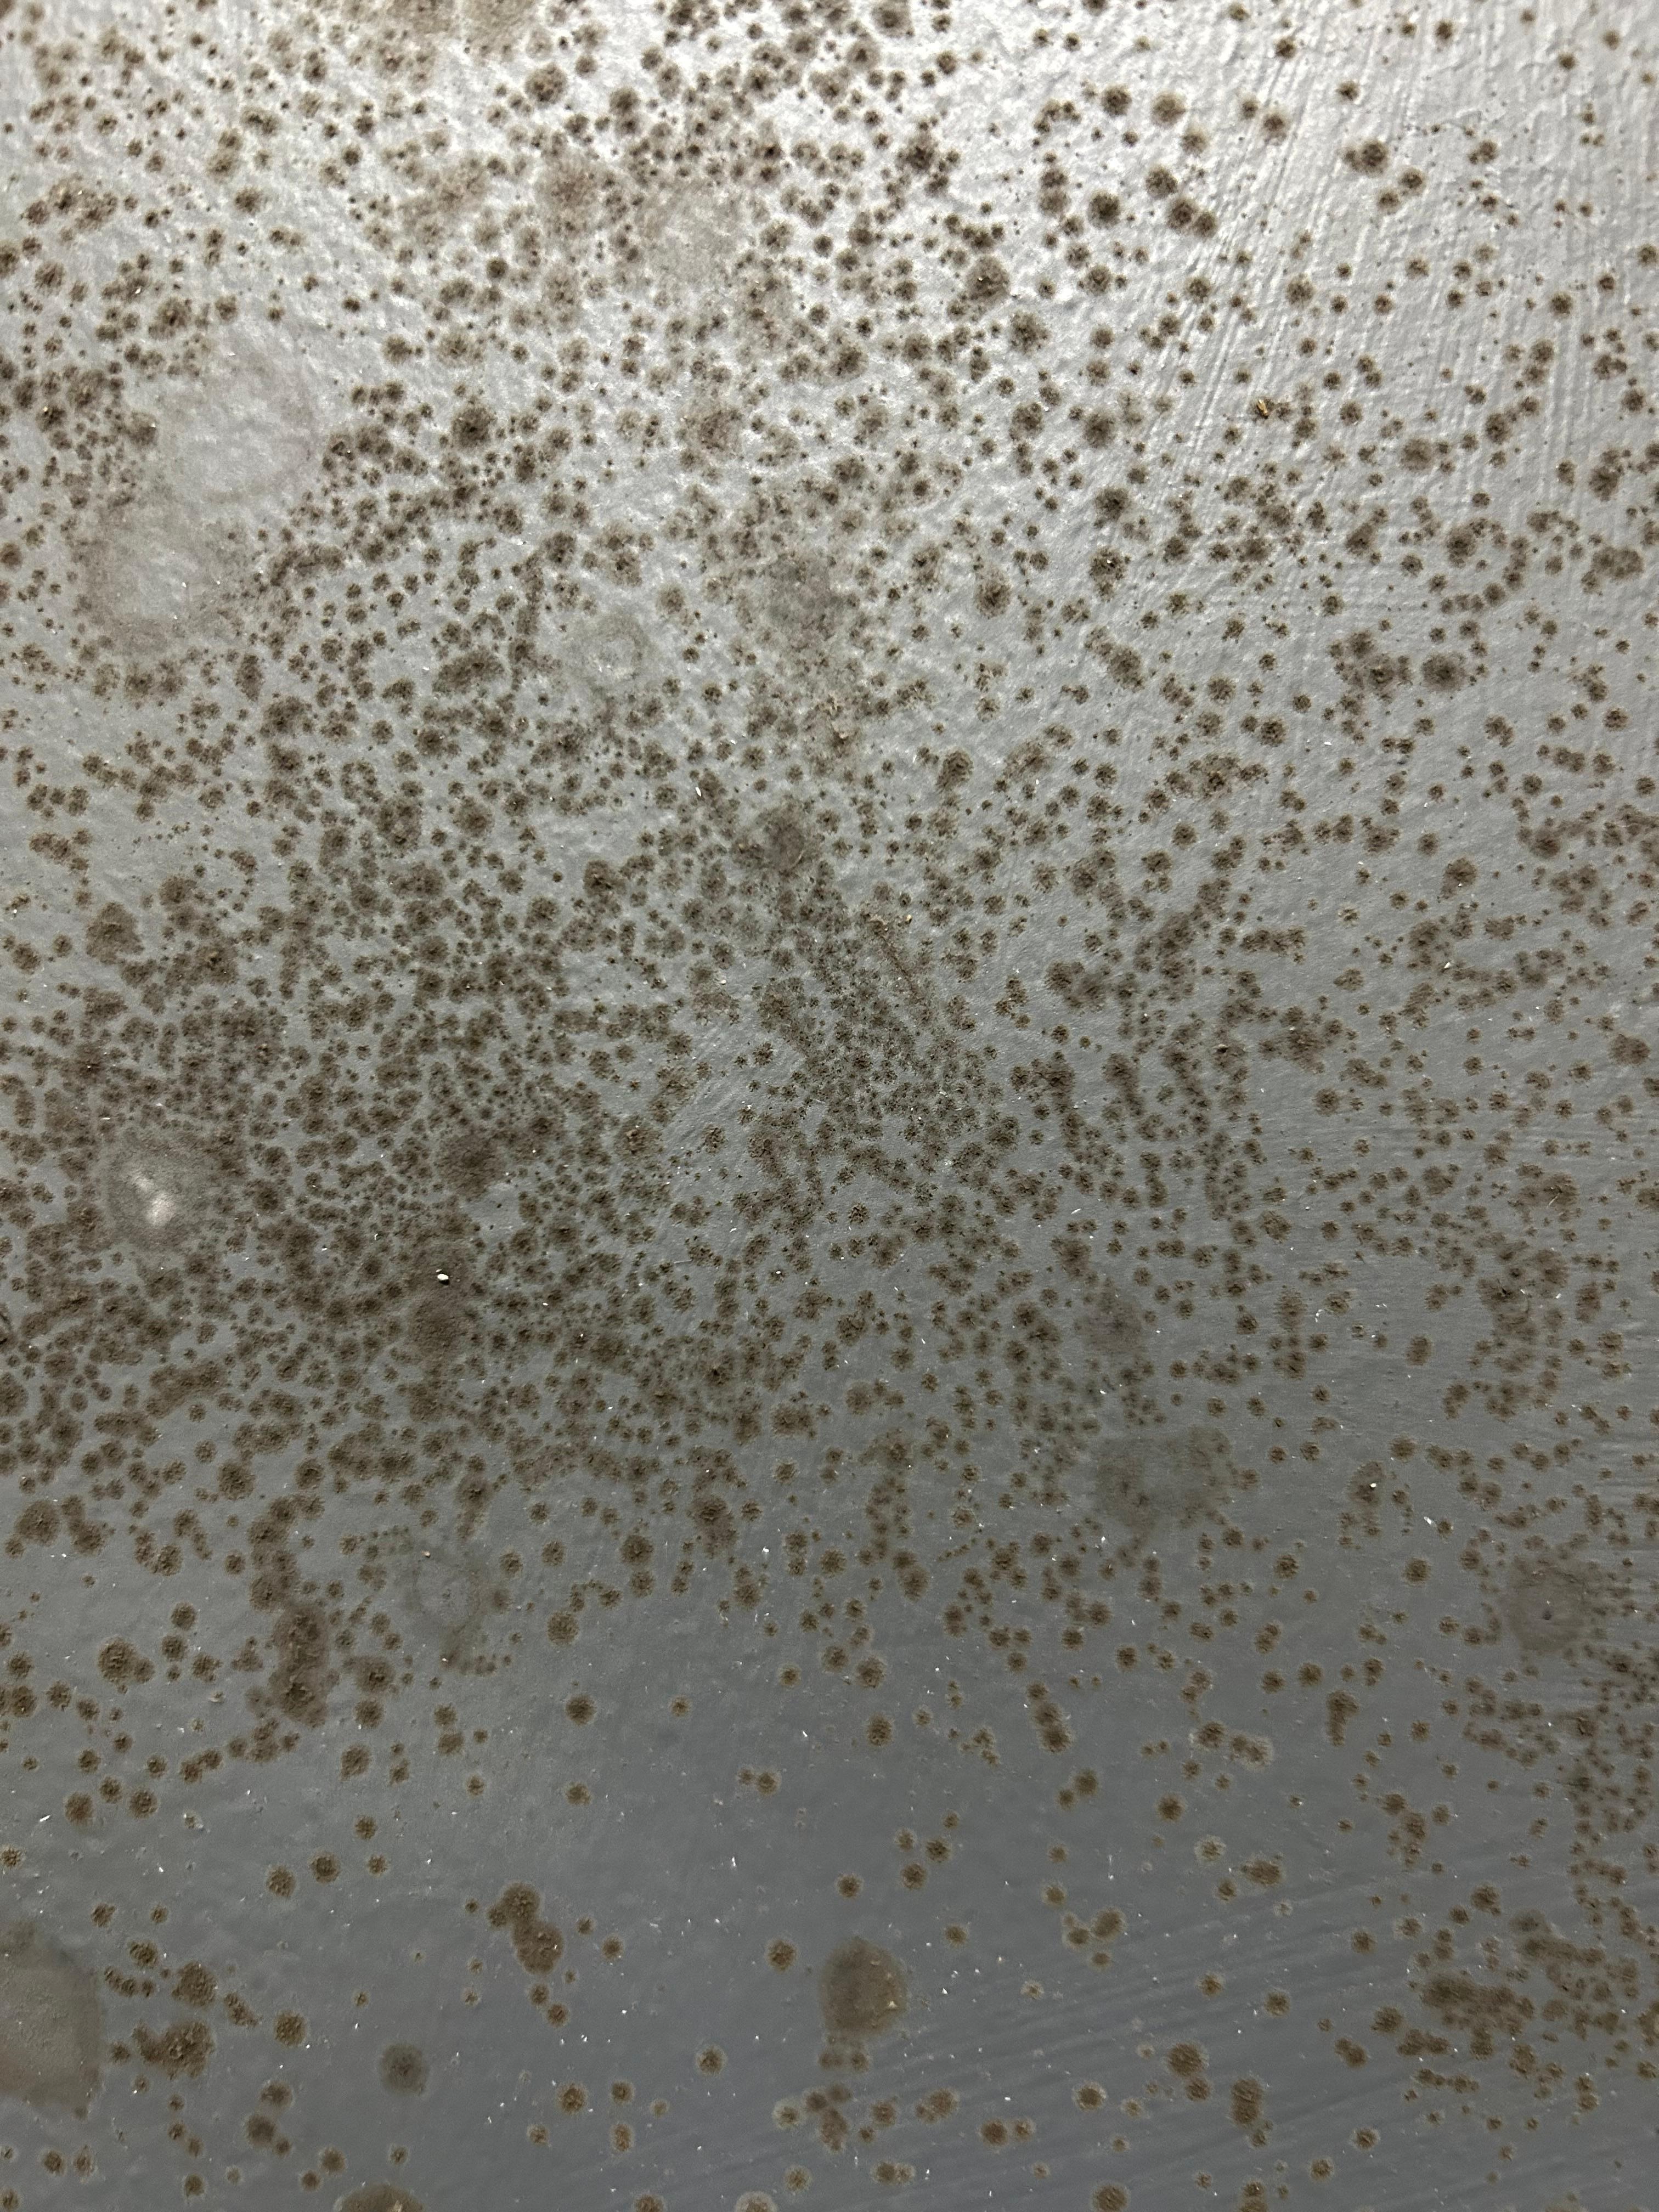

Apartment
Caravelle Tower Condo Rental: Walk to Beach
Photo gallery for Caravelle Tower Condo Rental: Walk to Beach





Reviews
8.8 out of 10
Excellent
1 bathroomSleeps 432.8 sq m
Popular amenities
Explore the area

Myrtle Beach, SC
- Place, Myrtle Beach Beaches1 min walk
- Place, Seventieth Avenue North Shopping Center7 min walk
- Place, Deephead Swash9 min walk
- Airport, Myrtle Beach, SC (MYR-Myrtle Beach Intl.)14 min drive
Rooms & beds
0 bedrooms (sleeps 4)
Studio
1 King Bed and 1 Double Sofa Bed
1 bathroom
Full Bathroom
Spaces
Kitchen
Balcony
About this property
Caravelle Tower Condo Rental: Walk to Beach
Add dates for prices
Have a question?
Get instant answers with AI powered search of property information and reviews.
Similar properties

Over-sized Luxury Balcony (sectional sofa!), Modern Style in the Golden Mile
Over-sized Luxury Balcony (sectional sofa!), Modern Style in the Golden Mile
- Ocean view
- Pool
- Spa pool
- Kitchen
9.6 out of 10, Exceptional, (50 reviews)
House Rules
Check in after 4:00 PM
Minimum age to rent: 18
Check out before 10:00 AM
Children
Children allowed: ages 0–17
Events
No events allowed
Pets
No pets allowed
Smoking
Smoking is not permitted
Important information
You need to know
Extra-person charges may apply and vary depending on property policy
Government-issued photo identification and a credit card, debit card or cash deposit may be required at check-in for incidental charges
Special requests are subject to availability upon check-in and may incur additional charges; special requests cannot be guaranteed
On-site parties or group events are strictly prohibited
Host has indicated that there is a carbon monoxide detector on the property
Host has indicated that there is a smoke detector on the property
Safety features at this property include a fire extinguisher and a first aid kit
About the area
Myrtle Beach
Located in Myrtle Beach, this apartment is near the beach. Broadway at the Beach and Barefoot Landing are worth checking out if shopping is on the agenda, while those wishing to experience the area's natural beauty can explore Myrtle Beach Beaches and Myrtle Beach State Park. SkyWheel Myrtle Beach and Ripley's Aquarium are not to be missed. Take the opportunity to explore the area for water adventures such as power boating.

Myrtle Beach, SC
What's nearby
- Myrtle Beach Beaches - 1 min walk - 0.0 km
- Seventieth Avenue North Shopping Center - 7 min walk - 0.7 km
- Deephead Swash - 9 min walk - 0.8 km
- Hall Of Heroes - 9 min walk - 0.8 km
- Cane Patch Par 3 & Driving Range - 10 min walk - 0.9 km
Getting around
Restaurants
- Fiesta Mexicana - 6 min walk
- Salt And Lime - 8 min walk
- Circle K - 14 min walk
- Crabby George's Calabash Seafood Buffet - 19 min walk
- Crave - 2 min drive
Frequently asked questions
Reviews
8.8
Excellent
Reviews are presented in chronological order, subject to a moderation process, and verified unless otherwise labelled.
Learn moreOpens in a new window8.0/10
Cleanliness
10/10
Property conditions & facilities
10/10
Check-in
9.0/10
Communication
9.2/10
Location
8.4/10
Listing accuracy
Reviews
Verified
23 June 2025
Liked: Cleanliness, check-in, communication, location, listing accuracy
Stayed 2 nights in Jun 2025
Verified
10/10 Excellent
Samantha D.
19 Oct 2024
Liked: Cleanliness, check-in, communication, location, listing accuracy
Getaway
Samantha D.
Stayed 6 nights in Oct 2024
Verified
10/10 Excellent
Michelle B.
6 July 2024
Liked: Cleanliness, check-in, communication, location, listing accuracy
Wonderful Stay! Clean and easy walk to the beach.
Michelle B.
Stayed 19 nights in Jun 2024
From a partner site
6/10 Okay
Willie
23 July 2024
My review
Willie
From a partner site
10/10 Excellent
Yulia
16 Aug 2024
Everything was great
Yulia
Stayed 2 nights in Jul 2024
Verified
10/10 Excellent
lakell w.
25 June 2023
Liked: Cleanliness, check-in, communication, location, listing accuracy
Weekend getaway
lakell w.
Stayed 2 nights in Jun 2023
From a partner site
10/10 Excellent
LAKELL
3 July 2023
Getaway
LAKELL
Verified
2/10 Terrible
Deserae M.
12 Aug 2025
Liked: Check-in
Disliked: Cleanliness, communication, listing accuracy
Weekend Getaway

Deserae M.
Stayed 2 nights in Aug 2025
Verified
10/10 Excellent
James
16 Aug 2025
Liked: Cleanliness, property conditions & facilities, communication
James
Stayed 3 nights in Aug 2025
Verified
10/10 Excellent
Lorena M.
6 July 2025
Lorena M.
Stayed 2 nights in Jun 2025
About the host
Hosted by Evolve
Languages:
English, French, German, Spanish
Tell us how we can improve our siteShare feedback




























